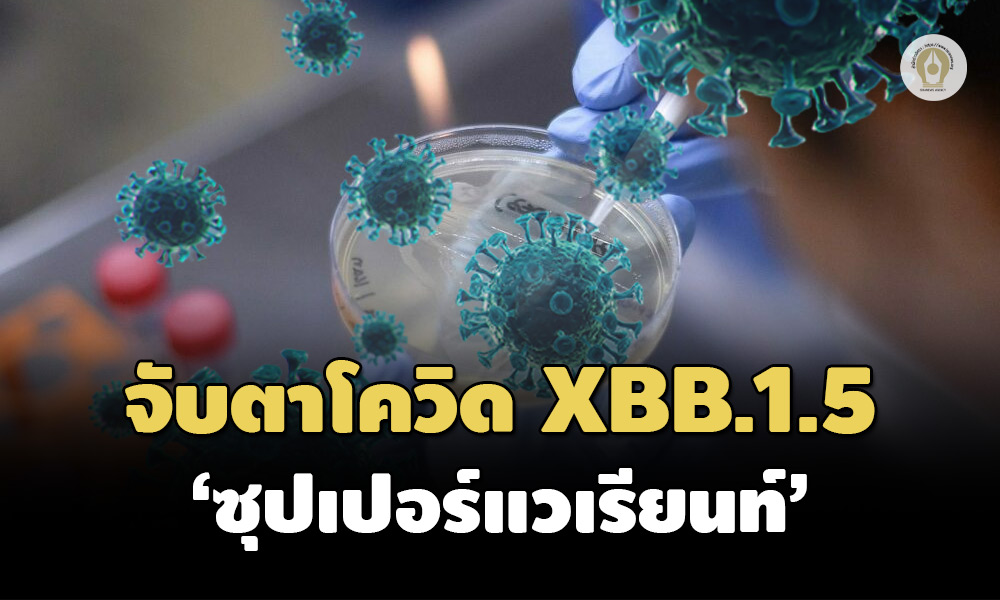

ศูนย์จีโนมฯ เปิด 18 ข้อหนุนจับตาโควิด 'ซุปเปอร์แวเรียนท์' XBB.1.5 คาดเป็นสายพันธุ์หลักปี 66 หลังระบาดพุ่งในอเมริกา ยันการตรวจด้วย ATK, RT-PCR ยาที่มียังใช้ได้
หมายเหตุสำนักข่าวอิศรา (www.isranews.org): เมื่อวันที่ 2 ม.ค. 2566 ศูนย์จีโนมทางการแพทย์ คณะแพทยศาสตร์โรงพยาบาลรามาธิบดี มหาวิทยาลัยมหิดล โพสต์ข้อมูลผ่านเฟซบุ๊ก Center for Medical Genomics ถึง 18 คุณสมบัติสำคัญของโควิด “ซุปเปอร์แวเรียนท์ (super-variant): XBB.1.5” ที่ควรทราบว่า
ศูนย์ควบคุมโรคติดต่อสหรัฐอเมริกา (Centers for Disease Control and Prevention, CDC)เมื่อวันที่ 30 ธันวาคม 2565 แถลงว่าได้เกิดการแพร่ระบาดของโอมิครอน “XBB.1.5” ในสหรัฐอเมริกาเป็นสองเท่าในเวลาเพียง 1 สัปดาห์ ปัจจุบันมีส่วนแบ่งการระบาดในผู้ติดเชื้อรายใหม่ถึง 40.5%
คาดว่าโอมิครอนลูกผสม XBB.1.5 จะกลายเป็นสายพันธุ์หลักที่ระบาดไปทั่วโลกอย่างรวดรเร็วในปี 2566

ทางศูนย์จีโนมฯ รพ. รามาธิบดีขอสรุป 18 คุณสมบัติสำคัญของโอมิครอน XBB.1.5 ที่น่าสนใจดังนี้
1. ต้นตระกูลของ XBB.1.5 คือโอมิครอน BA.2, เป็นสายพันธุ์ลูกผสม (recombinant) ระหว่างโอมิครอนสองสายพันธุ์คือ BJ.1 และ BM.1.1.1

2. มีวิวัฒนาการกลายพันธุ์ต่างจาก XBB.1 ในส่วนของโปรตีนหนาม 1 ตำแหน่งคือ “F486P”

3. เป็นสายพันธุ์ที่หลบเลี่ยงภูมิคุ้มกันได้ดีที่สุดสายพันธุ์หนึ่งในปัจจุบัน
4. จับยึดกับผิวเซลล์บริเวณโปรตีน ACE-2 ของผู้ติดเชื้อได้แน่นที่สุดสายพันธุ์หนึ่ง ทำให้เป็นสายพันธุ์ที่แทรกรุกรานเข้าสู่เซลล์ได้ดีที่สุดในปัจจุบัน

5. XBB.1.5 หลบเลี่ยงต่อภูมิคุ้มกันแบบผสม (hybrid immunity) อันเกิดจากการฉีดวัคซีนและการติดเชื้อตามธรรมชาติ) ได้ดีกว่าสายพันธุ์ดั้งเดิม, อู่ฮั่น ถึง 104 เท่า
6. ภูมิคุ้มกันแบบผสมจาก“การฉีดวัคซีนเอ็มอาร์เอ็นเอตามด้วยการติดเชื้อโอมิครอน BA.4/BA.5 ตามธรรมชาติ” สามารถป้องกันการติดเชื้อ XBB* ได้ดีกว่าการฉีดวัคซีนแบบเอ็มอาร์เอ็นเอตามด้วยการฉีดวัคซีนเข็มกระตุ้นด้วยวัคซีนสองสายพันธุ์ (bivalent)

7. ภูมิคุ้มกันแบบผสมจาก“การฉีดวัคซีนเชื้อตาย 3 เข็มตามด้วยการติดเชื้อโอมิครอน BF.7 ตามธรรมชาติ” สามารถป้องกันการติดเชื้อ XBB, XBB.1, XBB.1.5 ได้ใกล้เคียงกัน แต่ต่ำกว่าสายพันธุ์ดั้งเดิม, อู่ฮั่น อย่างมีนัยสำคัญ
8. ภูมิคุ้มกันแบบผสมจาก“การฉีดวัคซีนเอ็มอาร์เอ็นเอ 3 เข็มตามด้วยการติดเชื้อโอมิครอน BA.5 ตามธรรมชาติ” สามารถป้องกันการติดเชื้อ XBB, XBB.1, XBB.1.5 ได้ใกล้เคียงกัน (ภาพ6B) และใกล้เคียงกับกลุ่มผู้ที่ได้รับฉีดวัคซีนเชื้อตาย 3 เข็มตามด้วยการติดเชื้อโอมิครอน BF.7 ตามธรรมชาติ แต่ยังคงต่ำกว่าสายพันธุ์ดั้งเดิม, อู่ฮั่น อย่างมีนัยสำคัญ

9. แม้ว่า XBB.1.5 จะหลบเลี่ยงภูมิคุ้มกันได้ใกล้เคียงกับ XBB และ XBB.1 แต่พบว่า XBB.1.5 สามารถจับกับตุ่มโปรตีน ACE-2 บนผิวเซลล์ผู้ติดเชื้อได้แน่นกว่า BA.2.75, BQ.1.1 และ XBB ทำให้ผลรวมสามารถแพร่ระบาดได้เหนือกว่า XBB, XBB.1 และโควิดทุกสายพันธุ์ที่กำลังระบาดในหลายประเทศ ทั่วโลก
10. การฉีดวัคซีนเข็มกระตุ้น เอ็มอาร์เอ็นเอรุ่นที่สอง(สองสายพันธุ์-bivalent booster) จะกระตุ้นภูมิคุ้มกันต่อ XBB ได้ดีกว่าการฉีดวัคซีนเข็มกระตุ้นรุ่นแรก(สายพันธุ์เดียว monovalent booster) จำนวนสองเข็ม และการฉีดวัคซีนเข็มกระตุ้นรุ่นแรก(สายพันธุ์เดียว monovalent booster) เพียงเข็มเดียวตามลำดับ

11. จากการถอดรหัสพันธุกรรมทั้งจีโนมของ XBB.1.5 ในช่วง 3 เดือนที่ผ่านมาพบว่า XBB.1.5 มีความได้เปรียบในการเติบโต-แพร่ระบาด (relative growth advantage) เหนือกว่าโอมิครอนทุกสายพันธุ์ที่แพร่ระบาดในขณะนี้ ประมาณ 109 %

12. จากการถอดรหัสพันธุกรรมทั้งจีโนมของ XBB.1.5 ในช่วง 3 เดือนที่ผ่านมาพบว่า XBB.1.5 มีความได้เปรียบในการเติบโต-แพร่ระบาด (relative growth advantage) เหนือกว่าโอมิครอน BA.5.2.1 (ซึ่งเป็นสายพันธุ์หลักแพร่ระบาดในหลายประเทศขณะนี้)ประมาณ 217 %

13. ATK และ PCR ยังใช้ตรวจโอมิครอน XBB.1.5 ได้ดี ไม่แตกต่างจากโอมิครอนสายพันธุ์ย่อยอื่นอย่างมีนัยสำคัญ
14. อาการความรุนแรง (severity) ไม่ต่างจาก XBB* อื่นอย่างมีนัยสำคัญ
15. จากฐานข้อมูลโควิดโลก “GISAID” ยังไม่พบโอมิครอน XBB.1.5 ในประเทศไทย
16. ยา(เม็ด)โมลนูพิราเวียร์ (Molnupiravir), ยา(เม็ด)แพกซ์โลวิด (Paxlovid: nirmatrelvir/ritonavir), ยา(ฉีด)เรมเดซิเวียร์ (remdesivir) ยังใช้ต้านโควิดทุกสายพันธุ์ได้ดีแม้จะมีการกลายพันธุ์บนส่วนหนามแหลมก็ตาม ปัจจุบันยังไม่พบเชื้อดื้อยา

17. XBB.1.5 ดื้อต่อยาฉีดสร้างภูมิคุ้มกันสำเร็จรูปทุกชนิดที่หลายประเทศมีใช้กันอยู่ในปัจจุบัน (ภาพ10)
18. ยังไม่มีข้อมูลทางคลินิกบ่งชี้ว่า XBB.1.5 ทำให้เกิดการติดเชื้อรุนแรง (severity) แตกต่างไปจากโอมิครอนสายพันธุ์อื่นอย่างมีนัยสำคัญ
โดยสรุป XBB.1.5 แพร่ได้รวดเร็วกว่าโควิดทุกสายพันธุ์ที่ระบาดในปัจจุบัน หลบเลี่ยงภูมิคุ้มทั้งจากการฉีดวัคซีนและการติดเชื้อตามธรรมชาติได้ดีที่สุด ส่วนโปรตีนหนาม (spike protein) มีแรงยึดเกาะกับผิวเซลล์ผู้ติดเชื้อได้แน่นมากที่สุดทำให้แพร่ติดต่อเข้าสู่เซลล์ได้โดยง่าย ดื้อ (resistant) ต่อยาฉีดสร้างภูมิคุ้มกันสำเร็จรูปทุกชนิดที่หลายประเทศมีใช้กันอยู่ ถูกยับยั้งหรือทำลาย(susceptible) ได้ด้วยยาต้านไวรัสทั้งชนิดเม็ดและชนิดฉีด ปัจจุบันยังไม่พบเชื้อดื้อยา ยังสามารถตรวจคัดกรองได้ดีด้วย ATK และ PCR
“รู้เขา รู้เรา รบร้อยครั้งก็จะไม่พ่ายแพ้ในทุกครั้ง”

Isranews Agency | สำนักข่าวอิศรา